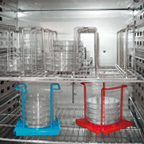
Petrischalengestell

WTB Binder BD 115 APT.Line
| Objektnummer | B00020368 |
|---|---|
| Numéro d'identification | 020368 |
| Nom de l'objet | WTB Binder BD 115 APT.Line |
| Statut | Stock unit |
Groupe de produits: Étuves d'incubation
Statut, conditions de livraison et de paiement
Vérification des appareils
Les appareils d’occasion sont vérifiés par Labexchange Service GmbH avant la livraison. Vous recevez des appareils entièrement fonctionnels.
Délai d'expédition
Les délais de livraison indiqués sont les plus rapides pour l’article en cause. Les délais de fait peuvent varier au cas par cas. Les délais de livraison définitifs sont indiqués dans la confirmation de commande.
Nous offrons des livraisons collectives par principe. Le délai de livraison s’oriente à l’article avec le délai de livraison le plus long. Une livraison partielle est possible par prix additionnel.
Méthodes d'expédition
Courrier, agences d'expédition, autocueillette, livraison par flotte de Labexchange
Conditions de livraison
Prix plus frais d’expédition. Les frais d’expédition indiqués sont à prévoir. Dérogations éventuelles sont possibles.
Si les coûts de transport ne sont pas spécifiés, s'il vous plaît demander séparément les frais de transport. Les frais de transport et d'emballage indiqués se réfèrent à l'itinéraire de transport le moins cher et sont sujets à des augmentations de coûts imprévues. En raison d'événements imprévisibles, les tarifs de transport et les délais de livraison peuvent changer à tout moment et doivent être adaptés à la situation actuelle. Incoterm codage selon les Incoterms 2010: Pour personnes qui viennent chercher les dispositifs elles-mêmes: EXW, pour les expéditions par voie maritime: CFR, par avion: CPT, d'autres expéditions: DAP. Remarque: Nous n'établissons pas des preuves préférentielles/EUR1. Dans le cas d’un enlèvement par vos soins/EXW de pays à l’intérieur ou à l’extérieur de la Union européenne, nous devons conserver 16% de TVA d’acheteur comme dépôt de garantie, jusqu’à ce que nous ayons reçu l’attestation de reception/la prevue de livraison.
Modalités de paiement
Nous n’acceptons pas le paiement par lettre de credit, PayPal, etc. Dans tous les cas le montant est payable sans déduction. Jusqu’au paiement complèt l’équipement reste notre propriété. Un escompte n’est pas accordé.
|
Pays |
Modalités de paiement possible |
Remarque |
|
DE, AT, CH |
Paiement par facture, prépaiement, par carte de credit |
Paiement par facture est possible pour clients professionnels. |
|
NL, BE, LU |
Paiement par facture, prépaiement, par carte de credit |
Paiement par facture est possible pour clients professionnels. |
|
Autre pays |
Prépaiement, par carte de credit |
|
Nos conditions de vente, de livraison et de paiement sont en vigueur. Vous pouvez télécharger les documents ici.
La vente intermédiaire nous est réservée.
Défintion des statuts
Tous articles sont d’occasion, sauf si explicitement défini comme « appareil neuf ».
|
Statut |
Condition |
Remarque |
|
Immédiatement disponible |
Occasion |
L’article a été déjà entièrement vérifié et peut être envoyé directement à vous. |
| En stock |
Occasion |
L'article est en notre stock, mais doit être vérifié avant la livraison par nos techniciens Vous recevez des articles entièrement fonctionnels. |
|
Publié |
Occasion |
L’article est toujours au l’offreur. Nous achetons, vérifions et en fin livrons l’article après votre commande. Le certificat de fonctionnement ainsi que le rapport de service sont inclus à la livraison. |
|
Appareil neuf |
Neuf |
C’est un dispositif neuf. L’article n’est pas utilisé et neuf d’usine. En ce qui concerne des article neufs, la garantie du fabricant est valable. |
|
Labprocure |
Occasion |
Responsable du contenu de l‘offre d’appareil est la société Labprocure GmbH, comme annonceur. Labprocure assume la responsabilité des offres annoncées ici ainsi que des photos et des textes d’offre inclus. Labprocure GmbH, Bruckstraße 58, 72393 Burladingen. |
Firma: Binder
Nachfolgende Abbildungen und Beschreibungen sind modellbezogen und aus Prospekten entnommen.
Sie geben nicht den Lieferumfang des Systems wieder.
Den exakten Lieferumfang entnehmen Sie bitte aus dem Angebotstext.
Wichtige Merkmale
- Hohe Temperaturgenauigkeit durch APT.line™ Technologie
- Freie Konvektion
- Controller mit LCD-Anzeige
- Elektromechanische Steuerung der Abluftklappe
- Innentür aus Sicherheitsglas (ESG)
- 2 verchromte Einschubgitter
- Stapelbar
- Integrierter Temperaturwählwächter Klasse 3.1 (DIN 12880) mit optischem Alarm
- Ergonomisches Griffdesign
Technische Daten
|
Temperaturbereich 5 °C über Raumtemperatur bis [°C] |
100 |
|
Räumliche Temperaturabweichung bei 37 °C [± K] |
0,4 |
|
Zeitliche Temperaturabweichung bei 37 °C [± K] |
0,1 |
|
Aufheizzeit auf 37 °C [min] |
55 |
|
Elektrische Daten |
|
|
Nennspannung [V] |
230 |
|
Netzfrequenz [Hz] |
50/60 |
|
Nennleistung [kW] |
0,35 |
|
Gerätesicherung [A] |
6,3 |
|
Phase (Nennspannung) |
1~ |
|
Maße |
|
|
Innenraumvolumen [L] |
112 |
|
Gerätegewicht netto (leer) [kg] |
53 |
|
Maximale Belastung pro Einschub [kg] |
20 |
|
Maße - Außenabmessungen |
|
|
Breite netto [mm] |
710 |
|
Höhe netto [mm] |
735 |
|
Tiefe netto [mm] |
605 |
|
Wandabstand hinten [mm] |
160 |
|
Wandabstand seitlich [mm] |
100 |
|
Maße - Innenabmessungen |
|
|
Breite [mm] |
510 |
|
Höhe [mm] |
530 |
|
Tiefe [mm] |
420 |
|
Maße - Türen |
|
|
Außentüren |
1 |
|
Umweltrelevante Daten |
|
|
Energieverbrauch bei 37 °C |
25 Wh/h |